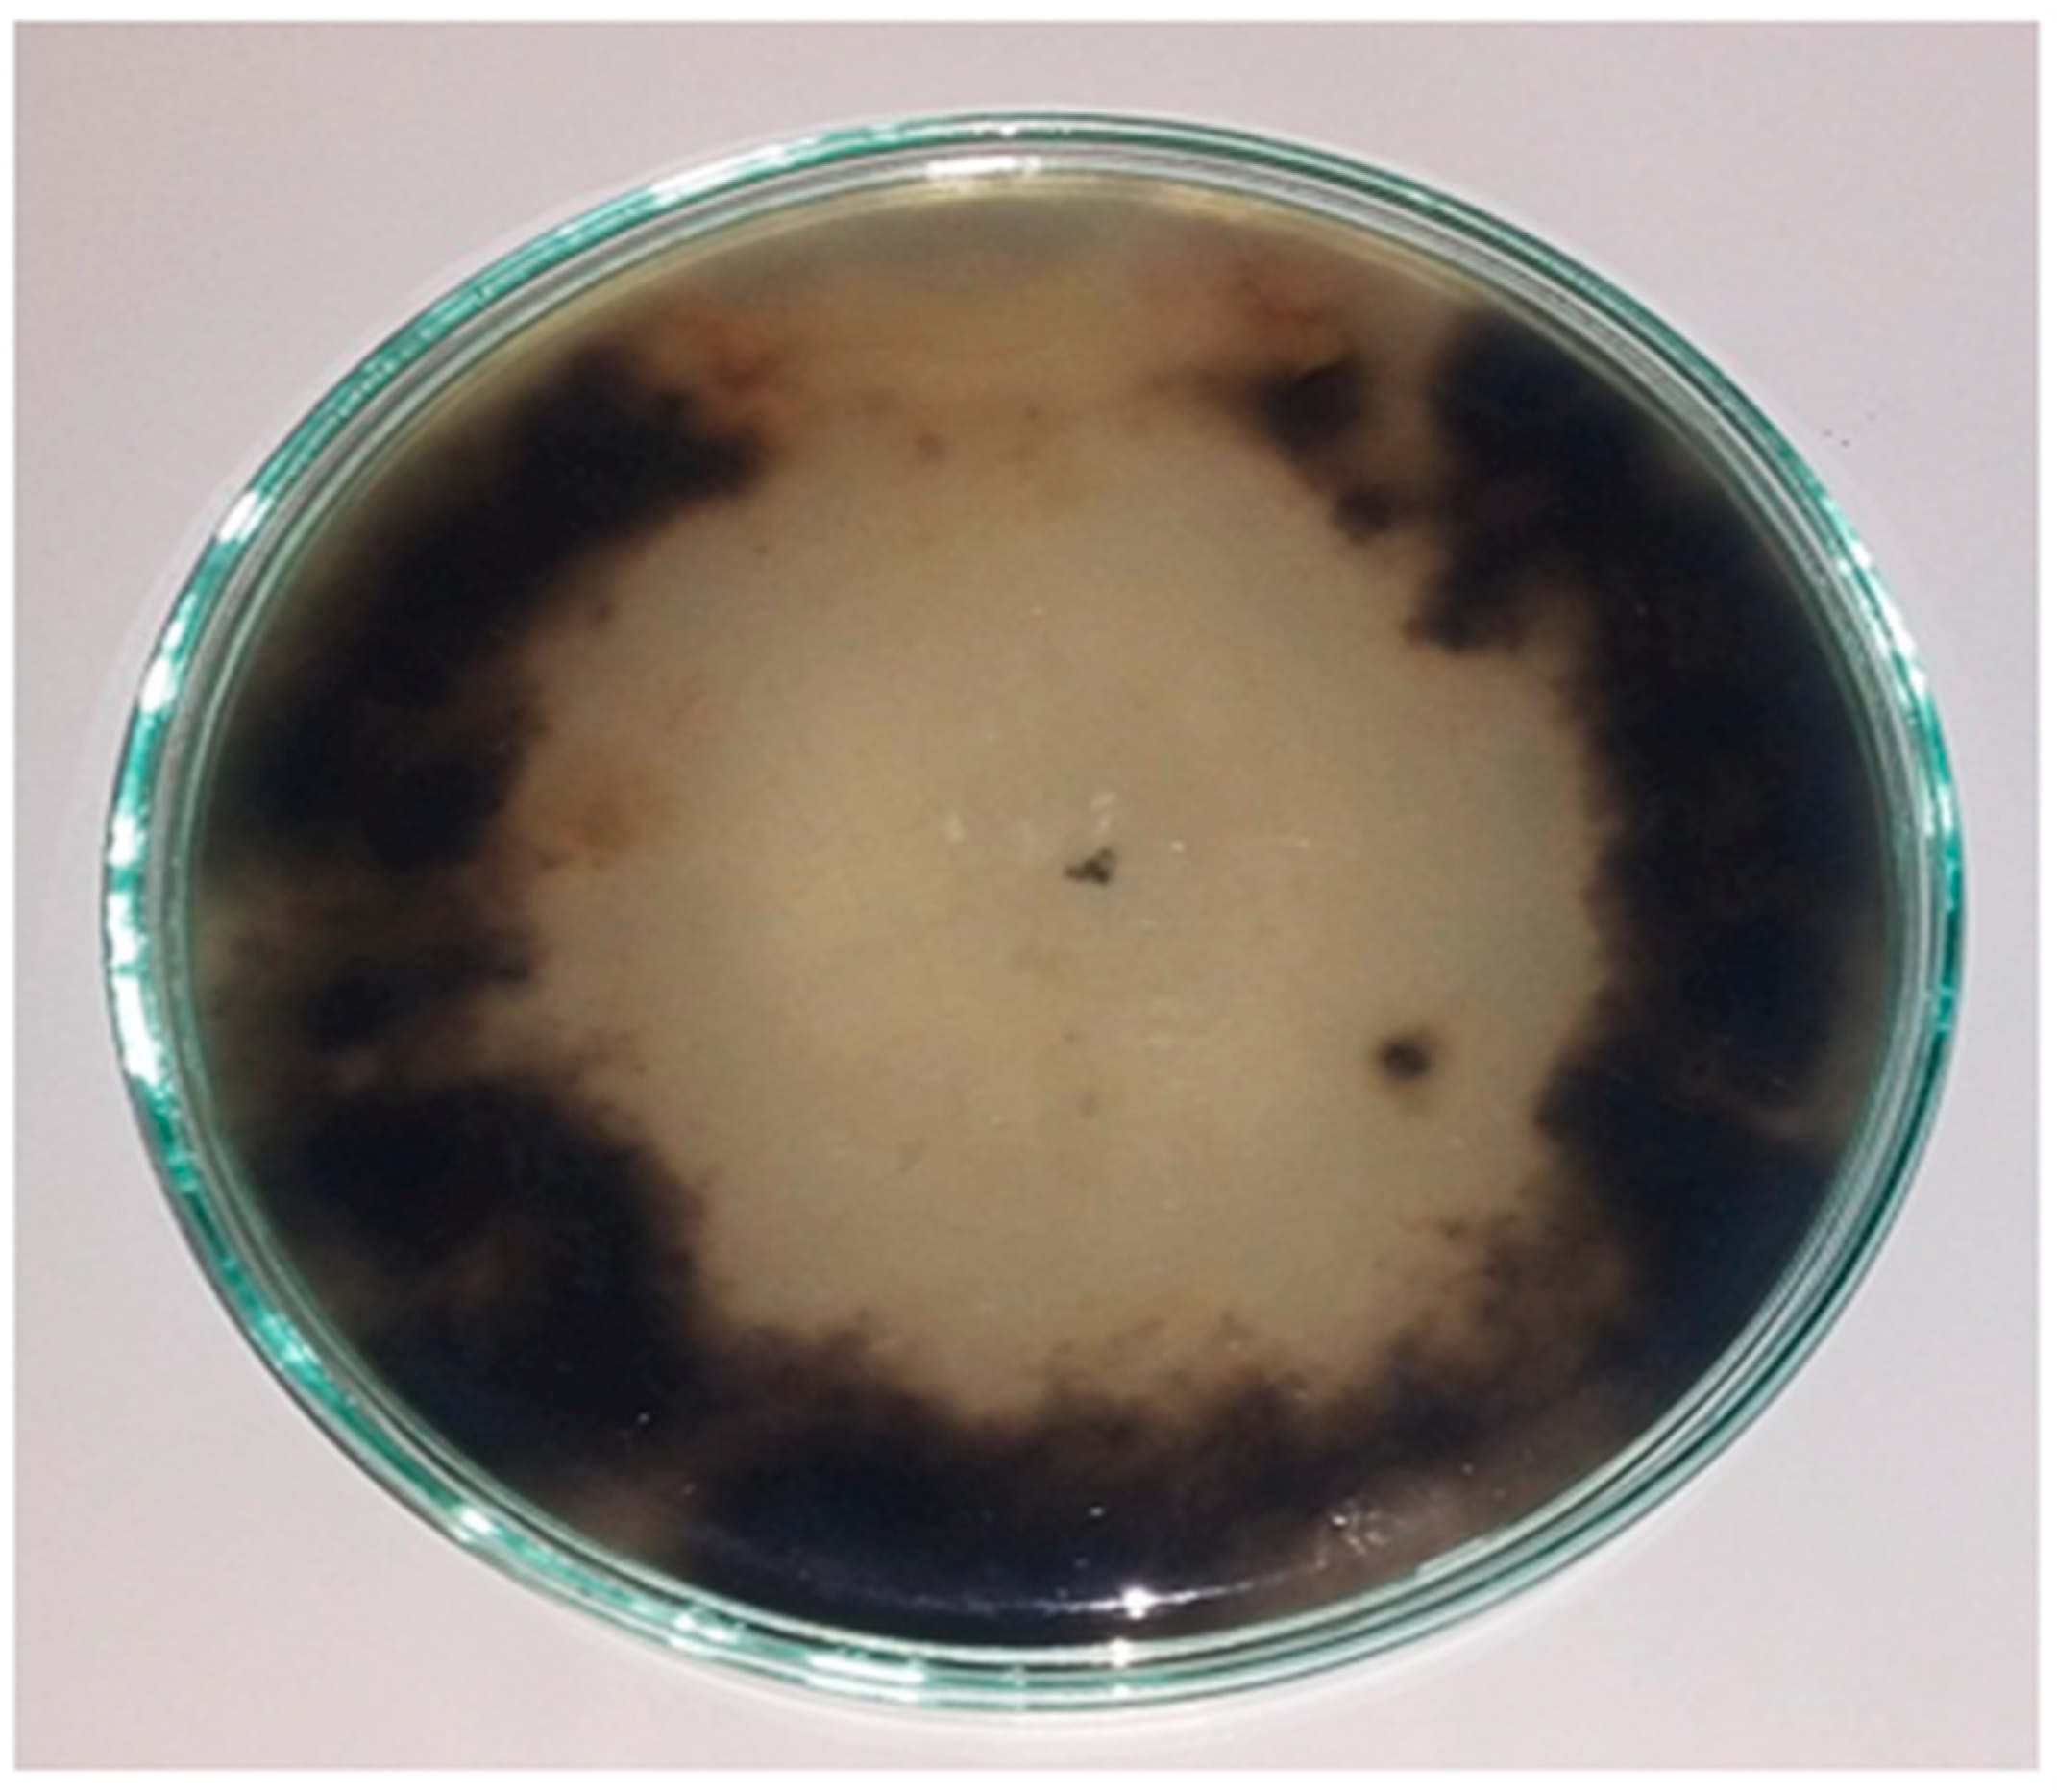
Plants 10 01846 g005
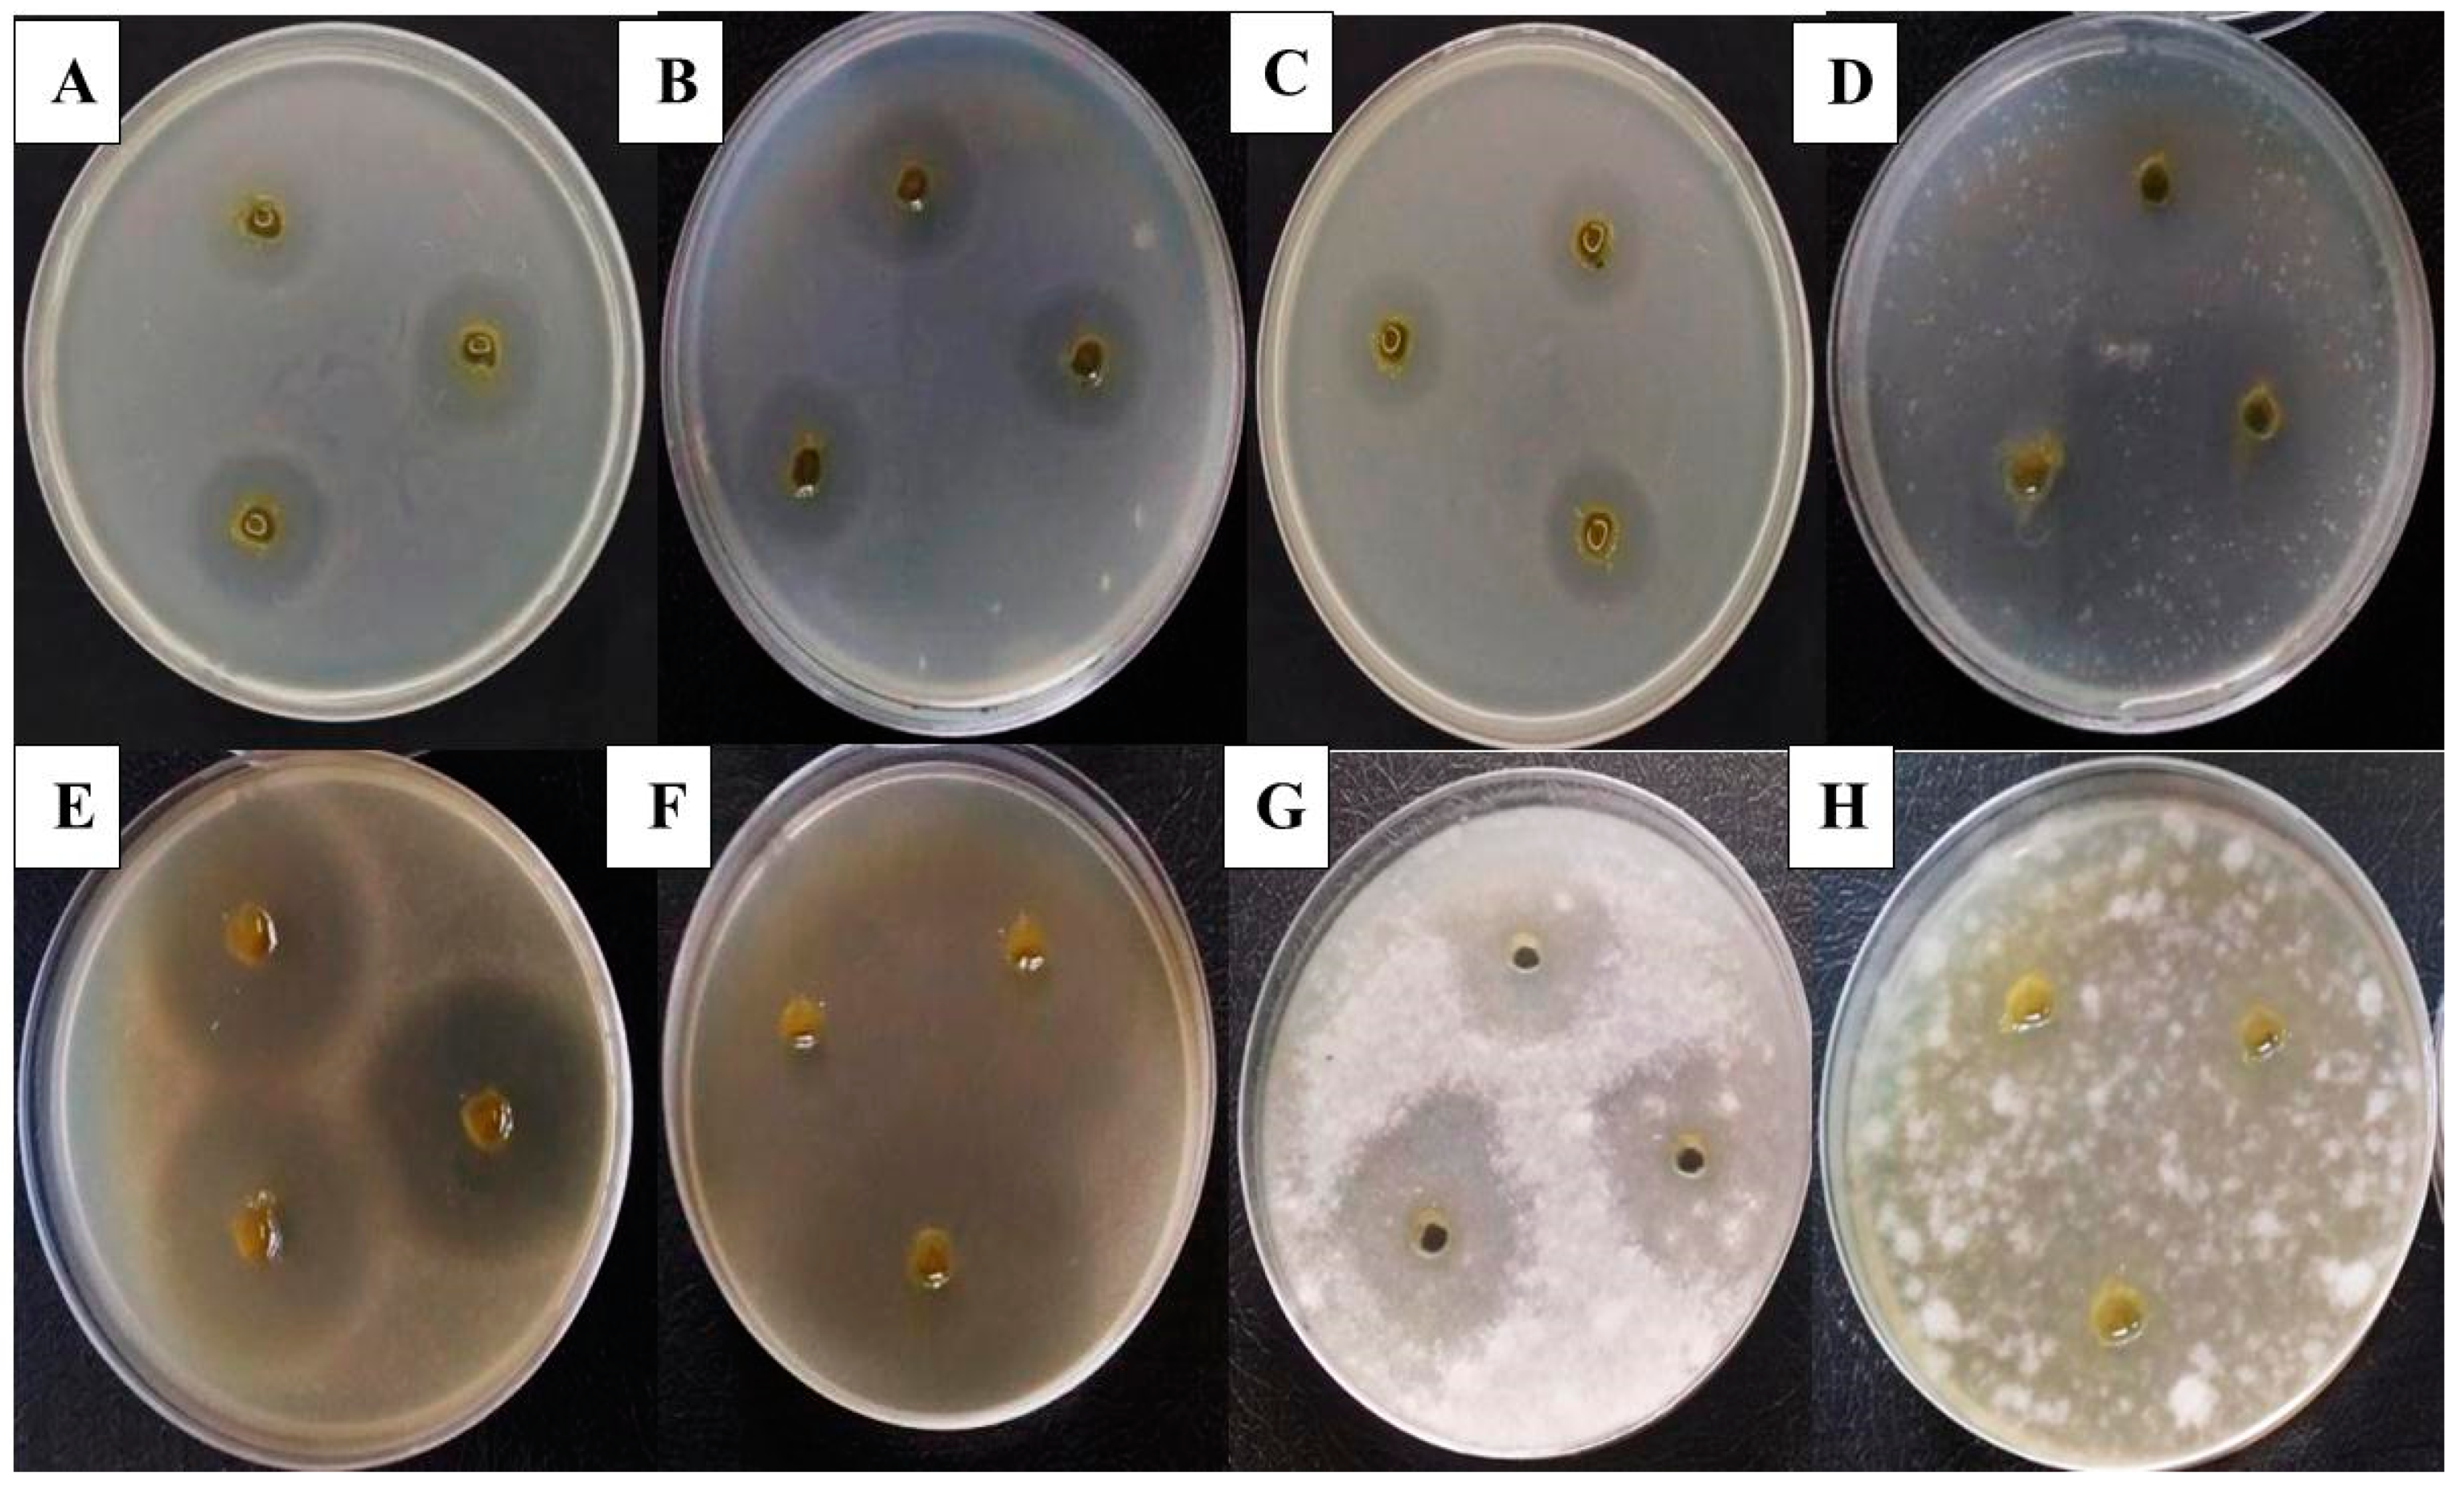
Plants 10 01846 g013

Controlling Alternaria cerealis MT808477 Tomato Phytopathogen by Trichoderma harzianum and Tracking the Plant Physiological Changes
Abstract
1. Introduction
2. Results
2.1. Pathogenicity of Alternaria cerealis in Tomato Plants
2.2. Morphological and Molecular Identification of Alternaria cerealis
2.3. Alternaria cerealis Growth Inhibition
2.4. Effect of Infection Period on the Total Phenol Production of Tomato Leaves during the Biological Control
2.5. Effect of Infection Period on the Total Flavonoid Production of Tomato Leaves during the Biological Control
2.6. Effect of Infection Period on the Total Terpenoids Production of Tomato Leaves during the Biological Control
2.7. Effect of Infection Period on the Total Antioxidant Contents of Production Tomato Leaves during the Biological Control
2.8. Effect of Infection Period on the Malondialdehyde Production of Tomato Leaves during the Biological Control
2.9. Effect of Infection Period on Catalases (CAT) and Peroxidase (POX) Antioxidant during the Biological Control
2.10. Antimicrobial Activity
3. Discussion
4. Materials and Methods
4.1. Pathogen Isolation
4.2. Phytopathogenic Ability
4.3. Tissue Processing for Light Microscopy
4.4. Scanning Electron Microscopy
4.5. Alternaria cerealis Morphological Identification
4.6. Alternaria cerealis Genetic Identification
4.6.1. DNA Extraction
4.6.2. PCR and Sequencing of ITS
4.6.3. Alignments and Phylogenetic Analyses
4.7. Inhibition of A. cerealis (MT808477) Using Saprophytic Trichoderma harzianum
4.8. Greenhouse Experiment
4.8.1. Soil Accommodation
4.8.2. Experimental Design
4.9. Physiological Analysis of Plants
4.9.1. Determination of Total Phenol
4.9.2. Total Flavonoid Determination
4.9.3. Total Terpenoid Determination
4.9.4. Total Antioxidant Determination
4.9.5. Determination of Malondialdehyde (MDA)
4.9.6. Determination of Catalases (CAT) and Peroxidase (POX) Antioxidant
4.10. Antimicrobial Activity
4.11. Statistical Analysis
5. Conclusions
Author Contributions
Funding
Institutional Review Board Statement
Informed Consent Statement
Data Availability Statement
Acknowledgments
Conflicts of Interest
References
- Chaudhary, P.; Sharma, A.; Singh, B.; Nagpal, A.K. Bioactivities of phytochemicals present in tomato. J. Food Sci. Technol. 2018, 55, 2833–2849. [Google Scholar] [CrossRef]
- Chaerani, R.; Groenwold, R.; Stam, P.; Voorrips, R.E. Assessment of early blight (Alternaria solani) resistance in tomato using a droplet inoculation method. J. Gen. Plant. Pathol. 2007, 73, 96–103. [Google Scholar] [CrossRef]
- Kokaeva, L.Y.; Belosokhov, A.F.; Doeva, L.Y.; Skolotneva, E.S.; Elansky, S.N. Distribution of Alternaria species on blighted potato and tomato leaves in Russia. J. Plant. Dis. Prot. 2018, 125, 205–212. [Google Scholar] [CrossRef]
- Blancard, D. Tomato Diseases: Identification, Biology and Control.: A Colour Handbook; CRC Press: Boca Raton, FL, USA, 2012. [Google Scholar]
- Shoresh, M.; Harman, G.E.; Mastouri, F. Induced systemic resistance and plant responses to fungal biocontrol agents. Annu. Rev. Phytopathol. 2010, 48, 21–43. [Google Scholar] [CrossRef]
- Brotman, Y.; Lisec, J.; Méret, M.; Chet, I.; Willmitzer, L.; Viterbo, A. Transcript and metabolite analysis of the Trichoderma-induced systemic resistance response to Pseudomonas syringae in Arabidopsis thaliana. Microbiology 2012, 158, 139–146. [Google Scholar] [CrossRef] [PubMed]
- Zghair, Q.N.; Lal, A.A.; Mane, M.M.; Sobita, S. Effect of bioagents and fungicide against earlyblight disease of tomato (Lycopersicon esculentum L.). Int. J. Plant. Prot. 2014, 7, 330–333. [Google Scholar] [CrossRef]
- Lehmann, S.; Serrano, M.; L’Haridon, F.; Tjamos, S.E.; Metraux, J.P. Reactive oxygen species and plant resistance to fungal pathogens. Phytochemistry 2015, 112, 54–62. [Google Scholar] [CrossRef]
- Baxter, A.; Mittler, R.; Suzuki, N. ROS as key players in plant stress signalling. J. Exp. Bot. 2014, 65, 1229–1240. [Google Scholar] [CrossRef] [PubMed]
- Xu, X.; Qin, G.; Tian, S. Effect of microbial biocontrol agents on alleviating oxidative damage of peach fruit subjected to fungal pathogen. Int. J. Food Microbiol. 2008, 126, 153–158. [Google Scholar] [CrossRef]
- Ejike, C.E.; Gong, M.; Udenigwe, C.C. Phytoalexins from the Poaceae: Biosynthesis, function and prospects in food preservation. Int. Food Res. J. 2013, 52, 167–177. [Google Scholar] [CrossRef]
- Sharifi-Rad, M.; Varoni, E.M.; Iriti, M.; Martorell, M.; Setzer, W.N.; del Mar Contreras, M.; Sharifi-Rad, J. Carvacrol and human health: A comprehensive review. Phytother. Res. 2018, 32, 1675–1687. [Google Scholar] [CrossRef]
- Othman, L.; Sleiman, A.; Abdel-Massih, R.M. Antimicrobial activity of polyphenols and alkaloids in Middle Eastern plants. Front. Microbial. 2019, 10, 1–28. [Google Scholar] [CrossRef] [PubMed]
- Mutha, R.E.; Tatiya, A.U.; Surana, S.J. Flavonoids as natural phenolic compounds and their role in therapeutics: An overview. FJPS 2021, 7, 1–13. [Google Scholar]
- Bamji, S.F.; Corbitt, C. Glyceollins: Soybean phytoalexins that exhibit a wide range of health-promoting effects. J. Funct. Foods 2017, 34, 98–105. [Google Scholar] [CrossRef]
- Awan, Z.A.; Shoaib, A.; Khan, K.A. Variations in total phenolics and antioxidant enzymes cause phenotypic variability and differential resistant response in tomato genotypes against early blight disease. Sci. Hortic. 2018, 239, 216–223. [Google Scholar] [CrossRef]
- Akhtar, K.P.; Saleem, M.Y.; Asghar, M.; Haq, M.A. New report of Alternaria alternata causing leaf blight of tomato in Pakistan. Plant. Pathol. 2004, 53, 816. [Google Scholar] [CrossRef]
- Choi, Y.P.; Paul, N.C.; Lee, H.B.; Yu, S.H. First record of Alternaria simsimi causing leaf spot on sesame (Sesamum indicum L.) in Korea. Mycobiology 2014, 42, 405–408. [Google Scholar] [CrossRef]
- Ni, L.; Punja, Z.K. Management of fungal diseases on cucumber (Cucumis sativus L.) and tomato (Solanum lycopersicum L.) crops in greenhouses using Bacillus subtilis. In Bacilli and Agrobiotechnology: Phytostimulation and Biocontrol; Springer: Cham, Switzerland, 2019; pp. 1–28. [Google Scholar]
- Chowdappa, P.; Kumar, S.M.; Lakshmi, M.J.; Upreti, K.K. Growth stimulation and induction of systemic resistance in tomato against early and late blight by Bacillus subtilis OTPB1 or Trichoderma harzianum OTPB3. Biol. Control. 2013, 65, 109–117. [Google Scholar] [CrossRef]
- Zin, N.A.; Badaluddin, N.A. Biological functions of Trichoderma spp. for agriculture applications. Ann. Agric. Sci. 2020, 65, 168–178. [Google Scholar] [CrossRef]
- El-Dabaa, M.A.T.; Abd-El-Khair, H. Applications of plant growth promoting bacteria and Trichoderma spp. for controlling Orobanche crenata in faba bean. Bull. Natl. Res. Cent. 2020, 44, 1–10. [Google Scholar] [CrossRef]
- Ramamoorthy, V.; Raguchander, T.; Samiyappan, R. Induction of defense-related proteins in tomato roots treated with Pseudomonas fluorescens Pf1 and Fusarium oxysporum f. sp. lycopersici. Plant. Soil 2002, 239, 55–68. [Google Scholar] [CrossRef]
- El-Khallal, S.M. Induction and modulation of resistance in tomato plants against Fusarium wilt disease by bioagent fungi (Arbuscular mycorrhiza) and/or hormonal elicitors (jasmonic acid & salicylic acid): 1-Changes in growth, some metabolic activities and endogenous hormones related to defence mechanism. Aust. J. Basic Appl. Sci. 2007, 1, 691–705. [Google Scholar]
- Martínez-Lüscher, J.; Torres, N.; Hilbert, G.; Richard, T.; Sánchez-Díaz, M.; Delrot, S.; Gomès, E. Ultraviolet-B radiation modifies the quantitative and qualitative profile of flavonoids and amino acids in grape berries. Phytochemistry 2014, 102, 106–114. [Google Scholar] [CrossRef]
- Nakabayashi, R.; Yonekura-Sakakibara, K.; Urano, K.; Suzuki, M.; Yamada, Y.; Nishizawa, T.; Saito, K. Enhancement of oxidative and drought tolerance in Arabidopsis by overaccumulation of antioxidant flavonoids. Plant. J. 2014, 77, 367–379. [Google Scholar] [CrossRef] [PubMed]
- Matta, A. Accumulation of phenols in tomato plants infected by different forms of Fusarium oxysporum. Phytopathology 1969, 59, 512–513. [Google Scholar]
- Abdel-Monaim, M.F. Evaluation of the accumulation of pathogenesis related (PR) proteins and phenolic compounds in response to biotic and abiotic elicitors as mechanism for immune response to Fusarium wilt disease in faba bean. J. Plant. Pathol. Microbiol. 2017, 8, 1–8. [Google Scholar]
- Zehra, A.; Meena, M.; Dubey, M.K.; Aamir, M.; Upadhyay, R.S. Synergistic effects of plant defense elicitors and Trichoderma harzianum on enhanced induction of antioxidant defense system in tomato against Fusarium wilt disease. Bot. Stud. 2017, 58, 1–14. [Google Scholar] [CrossRef]
- Zhou, R.; Kong, L.; Yu, X.; Ottosen, C.O.; Zhao, T.; Jiang, F.; Wu, Z. Oxidative damage and antioxidant mechanism in tomatoes responding to drought and heat stress. Acta Physiol. Plant. 2019, 41, 1–20. [Google Scholar] [CrossRef]
- Kużniak, E.; Skłodowska, M. Fungal pathogen-induced changes in the antioxidant systems of leaf peroxisomes from infected tomato plants. Planta 2005, 222, 192–200. [Google Scholar] [CrossRef]
- Hassan, M.E.; Abd El-Rahman, S.S.; El-Abbasi, I.H.; Mikhail, M.S. Changes in peroxidase activity due to resistance induced against faba bean chocolate spot disease. Egypt. J. Phytopathol. 2007, 35, 35–48. [Google Scholar]
- Sabatini, S.E.; Juárez, Á.B.; Eppis, M.R.; Bianchi, L.; Luquet, C.M.; de Molina, M.D.C.R. Oxidative stress and antioxidant defenses in two green microalgae exposed to copper. Ecotoxicol. Environ. Saf. 2009, 72, 1200–1206. [Google Scholar] [CrossRef]
- Lombardi, N.; Caira, S.; Troise, A.D.; Scaloni, A.; Vitaglione, P.; Vinale, F.; Woo, S.L. Trichoderma applications on strawberry plants modulate the physiological processes positively affecting fruit production and quality. Front. Microbial. 2020, 11, 1364. [Google Scholar] [CrossRef]
- Wang, Y.F.; Baloch, A.M.; Deng, J.; Baloch, A.W.; Hou, X.; Miao, R.; Zhang, R.S. Influence of Trichoderma inoculation on four crucial defense-related enzymes and leaf soluble protein level of poplar. Pak. J. Bot. 2020, 52, 879–884. [Google Scholar] [CrossRef]
- Zhang, Y.; De Stefano, R.; Robine, M.; Butelli, E.; Bulling, K.; Hill, L.; Schoonbeek, H.J. Different reactive oxygen species scavenging properties of flavonoids determine their abilities to extend the shelf life of tomato. Plant. Physiol. 2015, 169, 1568–1583. [Google Scholar] [PubMed]
- Dini, I.; Graziani, G.; Fedele, F.L.; Sicari, A.; Vinale, F.; Castaldo, L.; Ritieni, A. Effects of Trichoderma biostimulation on the phenolic profile of extra-virgin olive oil and olive oil by-products. Antioxidants 2020, 9, 284. [Google Scholar] [CrossRef]
- Youssef, S.A.; Tartoura, K.A.; Abdelraouf, G.A. Evaluation of Trichoderma harzianum and Serratia proteamaculans effect on disease suppression, stimulation of ROS-scavenging enzymes and improving tomato growth infected by Rhizoctonia solani. Biol. Control. 2016, 100, 79–86. [Google Scholar] [CrossRef]
- Keswani, C.; Bisen, K.; Singh, S.P.; Sarma, B.K.; Singh, H.B. A proteomic approach to understand the tripartite interactions between plant-Trichoderma-pathogen: Investigating the potential for efficient biological control. In Plant Soil and Microbes; Springer: Cham, Switzerland, 2016; pp. 79–93. [Google Scholar]
- Mastouri, F.; Björkman, T.; Harman, G.E. Seed treatment with Trichoderma harzianum alleviates biotic, abiotic, and physiological stresses in germinating seeds and seedlings. Phytopathology 2010, 100, 1213–1221. [Google Scholar] [CrossRef] [PubMed]
- EL-Tanany, M.M.; Hafez, M.A.; Ahmed, G.A.; El-Mageed, M.A. Efficiency of biotic and abiotic inducers for controlling tomato early blight. Middle East. J. 2018, 7, 650–670. [Google Scholar]
- Mayo-Prieto, S.; Marra, R.; Vinale, F.; Rodríguez-González, Á.; Woo, S.L.; Lorito, M.; Casquero, P.A. Effect of Trichoderma velutinum and Rhizoctonia solani on the Metabolome of Bean Plants (Phaseolus vulgaris L.). Int. J. Mol. Sci. 2019, 20, 549. [Google Scholar] [CrossRef]
- Kim, D.S.; Kwack, Y.; Chun, C. Secondary metabolite profiling in various parts of tomato plants. J. Hortic. Sci. Technol. 2014, 32, 252–260. [Google Scholar] [CrossRef]
- Kim, D.S.; Kwack, Y.; Lee, J.H.; Chun, C. Antimicrobial activity of various parts of tomato plants varied with different solvent extracts. Plant. Pathol. J. 2019, 35, 149–155. [Google Scholar] [CrossRef] [PubMed]
- Silva-Beltrán, N.P.; Ruiz-Cruz, S.; Cira-Chávez, L.A.; Estrada-Alvarado, M.I.; Ornelas-Paz, J.D.J.; López-Mata, M.A.; Márquez-Ríos, E. Total phenolic, flavonoid, tomatine, and tomatidine contents and antioxidant and antimicrobial activities of extracts of tomato plant. Int. J. Anal. Chem. 2015. [Google Scholar] [CrossRef] [PubMed]
- Meena, M.; Swapnil, P.; Upadhyay, R.S. Isolation, characterization and toxicological potential of Alternaria-mycotoxins (TeA, AOH and AME) in different Alternaria species from various regions of India. Sci. Rep. 2017, 7, 1–19. [Google Scholar] [CrossRef] [PubMed]
- Blagojević, J.D.; Vukojević, J.B.; Ivanović, Ž.S. Occurrence and characterization of Alternaria species associated with leaf spot disease in rapeseed in Serbia. Plant. Pathol. 2020, 69, 883–900. [Google Scholar] [CrossRef]
- Taia, W.K.; El-Etaby, M.O. Taxonomical Study in the Desert Plant Calligonum comosum LHer from Two Different Locations in Saudi Arabia. Asian J. Plant. Sci. 2006, 5, 570–579. [Google Scholar]
- Mahmoud, G.A.-E.; Osman, Y.A.; Abdel-Hakeem, S.S. Hydrolytic bacteria associated with natural helminth infection in the midgut of Red Sea marbled spinefoot rabbit fish Siganus rivulatus. Microb. Pathog. 2020, 147, 104404. [Google Scholar] [CrossRef]
- Simmons, E.G. Alternaria: An. Identification Manual; Biodiversity; CBS: Utrecht, The Netherlands, 2007; p. 775. [Google Scholar]
- White, T.J.; Bruns, T.; Lee, S.J.W.T.; Taylor, J. Amplification and direct sequencing of fungal ribosomal RNA genes for phylogenetics. PCR Protoc. Guide Methods Appl. 1990, 18, 315–322. [Google Scholar]
- Ibrahim, A.B.M.; Mahmoud, G.A.E. Chemical- vs sonochemicalassisted synthesis of ZnO nanoparticles from a new zinc complex for improvement of carotene biosynthesis from Rhodotorula toruloides MH023518. Appl. Organomet. Chem. 2021, 35, e6086. [Google Scholar] [CrossRef]
- Lefort, V.; Longueville, J.E.; Gascuel, O. SMS: Smart model selection in PhyML. Mol. Biol. Evol. 2017, 34, 2422–2424. [Google Scholar] [CrossRef]
- Solino, A.J.D.S.; Schwan-Estrada, K.R.F.; Oliveira, J.S.B.; Ribeiro, L.; Saab, M.F. Accumulation of phytoalexins in beans, soybeans and sorghum by fungal filtrates. Rev. Caatinga 2017, 30, 1073–1078. [Google Scholar] [CrossRef]
- Meda, A.; Lamien, C.E.; Romito, M.; Millogo, J.; Nacoulma, O.G. Determination of the total phenolic, flavonoid and proline contents in Burkina Fasan honey, as well as their radical scavenging activity. Food Chem. 2005, 91, 571–577. [Google Scholar] [CrossRef]
- Chang, C.C.; Yang, M.H.; Wen, H.M.; Chern, J.C. Estimation of total flavonoid content in propolis by two complementary colorimetric methods. J. Food Drug Anal. 2002, 10, 178–182. [Google Scholar]
- Fan, J.P.; He, C.H. Simultaneous quantification of three major bioactive triterpene acids in the leaves of Diospyros kaki by high-performance liquid chromatography method. J. Pharm. Biomed. Anal. 2006, 41, 950–956. [Google Scholar] [CrossRef] [PubMed]
- Prieto, P.L.; Pineda, M.; Aguilar, M. Spectrophotometric quantitation of antioxidant capacity through the formation of a phosphomolybdenum complex: Specific application to the determination of vitamin E. Anal. Biochem. 1999, 269, 337–341. [Google Scholar] [CrossRef] [PubMed]
- Hodges, D.M.; DeLong, J.M.; Forney, C.F.; Prange, R.K. Improving the thiobarbituric acid-reactive-substances assay for estimating lipid peroxidation in plant tissues containing anthocyanin and other interfering compounds. Planta 1999, 207, 604–611. [Google Scholar] [CrossRef]
- Lowry, O.H.; Rosebrough, N.J.; Farr, A.L.; Randall, R.J. Protein measurement with the folin phenol reagent. J. Biol. Chem. 1951, 193, 265–275. [Google Scholar] [CrossRef]
- Havir, E.A.; McHale, N.A. Biochemical and developmental characterization of multiple forms of catalase in tobacco leaves. Plant. Physiol. 1987, 84, 450–455. [Google Scholar] [CrossRef]
- Hammerschmidt, R.; Nuckles, E.M.; Kuć, J. Association of enhanced peroxidase activity with induced systemic resistance of cucumber to Colletotrichum lagenarium. Physiol. Plant Pathol. 1982, 20, 73–82. [Google Scholar] [CrossRef]

Publisher’s Note: MDPI stays neutral with regard to jurisdictional claims in published maps and institutional affiliations. |
© 2021 by the authors. Licensee MDPI, Basel, Switzerland. This article is an open access article distributed under the terms and conditions of the Creative Commons Attribution (CC BY) license (https://creativecommons.org/licenses/by/4.0/).
Share and Cite
Mahmoud, G.A.-E.; Abdel-Sater, M.A.; Al-Amery, E.; Hussein, N.A. Controlling Alternaria cerealis MT808477 Tomato Phytopathogen by Trichoderma harzianum and Tracking the Plant Physiological Changes. Plants 2021, 10, 1846. https://doi.org/10.3390/plants10091846
Mahmoud GA-E, Abdel-Sater MA, Al-Amery E, Hussein NA. Controlling Alternaria cerealis MT808477 Tomato Phytopathogen by Trichoderma harzianum and Tracking the Plant Physiological Changes. Plants. 2021; 10(9):1846. https://doi.org/10.3390/plants10091846
Chicago/Turabian StyleMahmoud, Ghada Abd-Elmonsef, Mohamed A. Abdel-Sater, Eshraq Al-Amery, and Nemmat A. Hussein. 2021. "Controlling Alternaria cerealis MT808477 Tomato Phytopathogen by Trichoderma harzianum and Tracking the Plant Physiological Changes" Plants 10, no. 9: 1846. https://doi.org/10.3390/plants10091846
APA StyleMahmoud, G. A.-E., Abdel-Sater, M. A., Al-Amery, E., & Hussein, N. A. (2021). Controlling Alternaria cerealis MT808477 Tomato Phytopathogen by Trichoderma harzianum and Tracking the Plant Physiological Changes. Plants, 10(9), 1846. https://doi.org/10.3390/plants10091846

